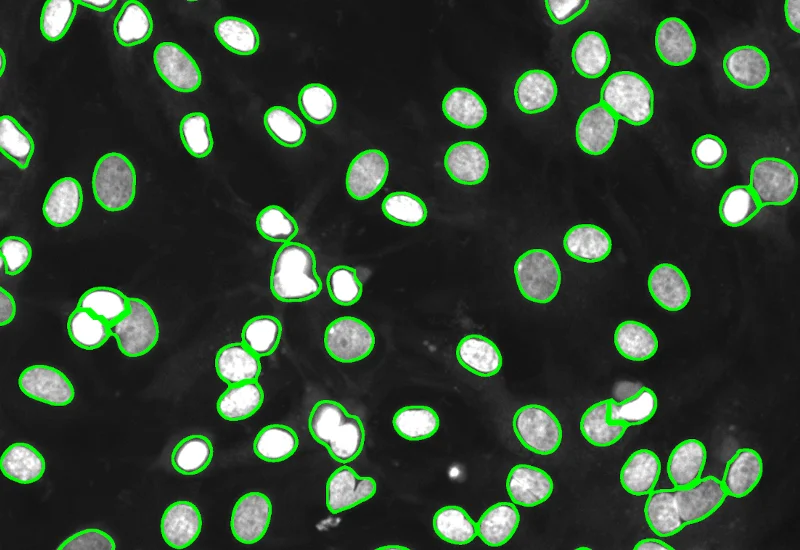

IF Cardio Cell Culture Dots
Segment cultured cardiac cells, detect cardiomyocytes and fibroblasts, and quantify dot markers (CISH/FISH) per cell, including cell counts and dot number, area, and mean intensity.
cardiology, cardiomyocytes, cell culture, fibroblasts, troponin red, FISH

The IF Cardio Cell Culture Dot App provides cell segmentation, detection of cardiomyocytes (based an appropriate stain e.g. Troponin Red) and fibroblasts within cultured cardio cells plus one dot marker (CISH, FISH). The App outputs parameters such as number of cardiomyocytes, fibroblasts and dotpos cardiomyocytes, fibroblasts as well as number, area (μm²) and mean intensity of dots per cell.
Agatha Ribeiro da Silva, Prof. Jose E. Krieger (Heart Institute, University Soa Paulo)

Original Image
Nuclei detection

Dot detection

Cardiomyocytes (red), fibroblasts (green)

Application Note
14 Oct, 2024
Quantitative Analysis of Cultured Cells

Webinar
19 Jan, 2024
Practical Approaches for Using Tissue Cytometry for Research Applications

White Paper
17 Oct, 2025
Integrative Multiomics Approach Unveils Systemic Dysfunction in Colorectal Cancer (CRC)

Application Note
14 Oct, 2024
Quantitative Analysis of Cultured Cells
We support the following file formats:
- TissueFAXS (aqproj)
- StrataFAXS II (vmic)
- PreciPoint (vmic, gtif)
- Generic BigTIFF Import
- Support for multipage BigTIFF files
- OME-TIFF
- JPEG, PNG, BMP, TIFF
- Zeiss (czi)
- Hamamatsu NanoZoomer (ndpi)
- Aperio (svs)
- Leica (scn)
- 3D HISTECH Pannoramic
- Mirax (mrxs)
- Olympus (vsi)
- More slide scanners to be added!
Related Apps

IF Cardio Cell Culture
Detect nuclei and identify cardiomyocytes in IF-stained cell cultures, reconstruct cytoplasmic masks, and quantify cardiomyocyte number, area, and marker intensity.
cardiology, cardiomyocytes, cell culture, fibroblasts, troponin red

IF Cell Culture - Osteoclast
Segment nuclei, identify multinucleated osteoclasts, and quantify cell number, nuclei per osteoclast, osteoclast area, and marker intensity within osteoclasts.
bone research, osteoclast, multinucleated cells, bone adsoprtion

IF Cytoskeleton
Detect cytoskeletal structures by specific stain, identify cytoplasm with additional markers, and export filament count (inside, outside, membrane), filament length, and total filament area.
actin, cytoskeleton, cortical fibres, microfilaments, stress fibres, cell culture, fluorescence

Custom App development
Perfectly tailored image analysis solutions for your research.
You have a specific research question that needs to be answered? We offer custom development of image analysis pipelines for specific tasks, be it detection of cellular phenotypes or quantification of tissue structures. After discussing your goals with one of our experts, you will get a ready-to-use App and be a step closer to an impactful publication.


